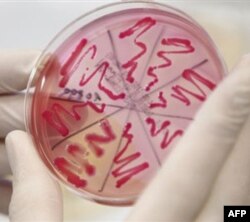
E.coli bakteriyasi

Yevropada 30 dan ziyod odamni hayotdan olib ketgan ichak infeksiyasi loviya ko’chatlaridan tarqalgani ma’lum bo’ldi.
Bir oy oldin Germaniya shimolida vujudga kelgan infeksiya bugunga kelib qo’shni davlatlarda ham aniqlandi. Kasallikni qo’zg’atuvchi ichak tayoqchalari bakteriyasidir. O’tkir buyrak yetishmovchiligi, ich o’tish, isitma, qolaversa o’limga yetaklashi mumkin.
Infeksiya sababini aniqlash ustida tadqiqotlar o’tgan oydan beri to’xtagani yo’q. Sinchkov tekshiruv mutaxassislarni Germaniya shimoli, Gamburg shahri yaqinidagi fermaga yetakladi. Teplitsada o’stirilgan loviya kasallik qo’zg’atuvchisi deb taxmin qilinmoqda.
Amerikada virus hozirgacha to’rt kishida aniqlangan, barchasi Germaniyada bo’lib qaytgan fuqarolar. Oshqozon-ichak xastaliklari bo’yicha ekspert Robin Chatkan infeksiya okeanning bu tomonida avj olishini ham kutavering deydi.
“Sabab esa oddiy - AQSh va Yevropa o’rtasida qatnov ko’p. Muammo ko’lami kelasi bir necha hafta mobaynida yuzaga chiqa boshlaydi. Xavotir shundaki, E-Coli bakteriyasining bu agressiv turi haqida ko’p narsa bilmaymiz”, - deydi mutaxassis.
Epidemiya o’chog’i Germaniyada buyrak faoliyati ishdan chiqqan yuzlab odam og'ir ahvolda kasalxonaga yotqizilgan. Esherixiya koli, ya’ni ichak tayoqchalari organizm uchun zararsiz, hatto foydali desa bo’ladi. Ammo shunday turlari borki, kuchli zaharlanishga olib keladi.
Pet Bak - oziq-ovqat sifati va xavfsizligi bilan shug’ullanuvchi tashkilot direktori. Uning nabirasi Kevin E-Coli bakteriyasi bilan zaharlangan ovqatni yeb, 2006 yilda vafot etgan. Hukumat qayerga qarayapti, bunday mahsulot bozorga chiqarilmasligi kerak, deydi u.
“Insoniyat, hayvonot dunyosi, tabiat – hammasi bir-biriga chambarchas bog’liq. Bu kasalliklar qayoqdan keladi degan savolga javob ham shu. Birinchi navbatda, go’sht va chorvachilik mahsulotlaridan”, - deydi faol.
Doktor Robin Chatkan fikricha, Amerikada oziq-ovqat xavfsizligini ta’minlash uchun yangi qonun-qoidalar ishlab chiqilishi zarur.
“Yevropada virus loviya ko’chatidan tarqalganini aniqlash uchun ancha vaqt ketdi. Bu orada qancha insonlar halok bo’ldi. Gap shundaki, E-Coli bakteriyasi ko’proq go’sht va chorvachilik mahsulotlaridan chiqadi deb taxmin qilinardi. Kasallik qo’zg’atuvchisi hozirda pomidor, bodring, loviya va boshqa sabzavotlarda ham topilyapti”.
AQSh Kasalliklarni nazorat qilish va oldini olish markazi butun mamlakat bo’ylab sog’liqni saqlash idoralarini ogohlikka chaqirdi. Virusni yuqtirgan odamlar haqida darhol ma’lumot berish so’raladi.
Shu bilan birga, xorijdan, ayniqsa Yevropadan import qilingan oziq-ovqat izchil tekshiruvdan o’tishi shart. Yaqinda qabul qilingan qonun bozorga sabzavot yetkazuvchi kompaniyalarga ham yangi talablar qo’yadi.
Shifokorlar deydiki, xaridor ham o’z salomatligi haqida o’ylasin. Turli kimyoviy moddalar bilan to’yintirilgan meva va poliz mahsulotlarini yaxshilab yuvmasdan iste’mol qilmang.
Yevropadagi vaziyatni kuzatib turgan jamoatchi faollar nazarida Amerika hukumati vaqtincha choralar bilan cheklanmasligi lozim. Go’sht kombinatlari va qassobxonalarda ham nazorat kuchaytirilmas ekan, xavf saqlanib qolaveradi.